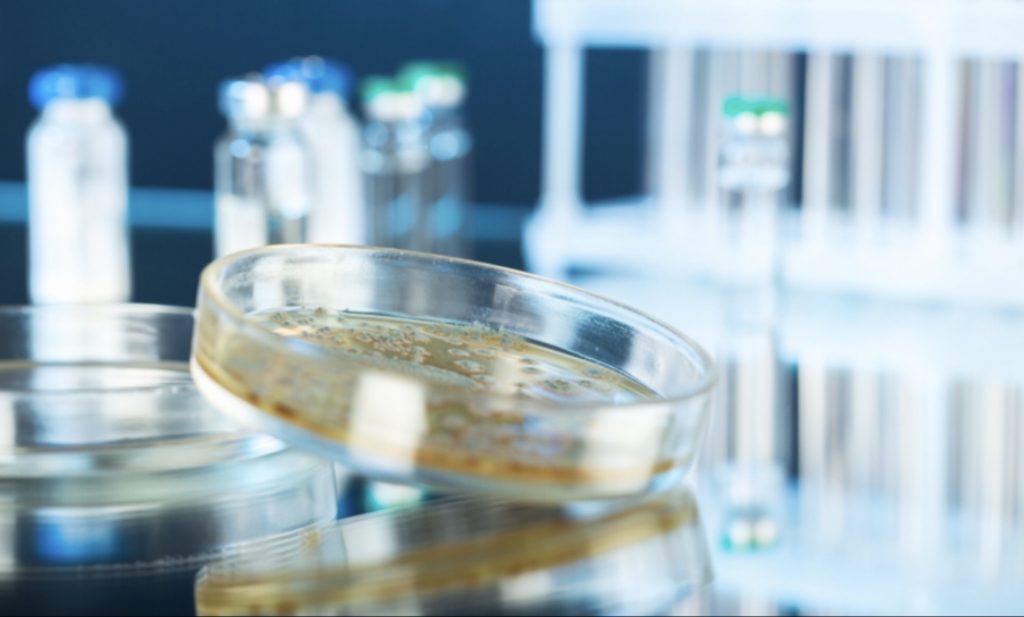
How One Non-Profit Uses Reserve Funds to Invest In ESG-Driven Companies – Environment + Energy Leader

Opinion
All across Washington, DC, and in cities around the world, non-profit organizations operate pursuing their missions. Some non-profits are focused on resolving environmental issues. Some are focused on addressing BIPOC and minority challenges. Others, like the Institute for the Advancement of Food and Nutrition Sciences, are focused on food and nutrition research, education and science.
Many of these non-profits have a reserve fund. This rainy day money aids them in navigating the challenging years when membership and donations are down. Additionally, these reserve funds represent another way that non-profit organizations can support the causes they believe in. These funds can be directed through the organization’s Investment Policy Statement – to ensure the purpose–driven actions of the non-profit organization are realized more fully.
Earlier this year, the Institute for the Advancement of Food and Nutrition Sciences (IAFNS) was launched as a new 501(c)(3) science-focused non-profit organization. As the organization considered its new identity—and how to ensure it could best realize and reinforce its goal of catalyzing science for positive change in the food and beverage ecosystem to advance public health — the Board quickly realized it needed to put its reserve money “where its mouth was.”
This purposeful decision by the Board was taken and now IAFNS investments are geared toward companies that operate with high environmental, social and governance (ESG) standards. Further, the investment portfolio does not include tobacco. (Tobacco companies are not allowed membership in IAFNS due to the clear adverse health impact of smoking.) How could we claim to live our values of scientific integrity, transparency, collaboration and public benefit if we did not reinforce those with our reserve fund investments?
Defining ESG Investment Policies
To drive this change and ensure we are living our values, we started by asking our investment advisers to conduct a confidential survey with our Board Finance Committee. Our Board members, from both the public sector and the private sector, voted and identified the specific criteria IAFNS wanted to avoid and criteria to emphasize in order to have IAFNS’ values reflected in its investments. (A key point of emphasis in the survey is that the values are to be reflected are organizational values not personal ones.)
Next, the Board Finance Committee determined whether direct or indirect exposure to the companies IAFNS wanted to exclude or promote in the portfolio was acceptable. Direct exposure comes from buying individual companies’ securities on the open market, while indirect exposure reflects owning shares of a mutual fund or Exchange Traded Fund (ETF) where a fund manager purchases securities as holdings of the fund.
Working with advisers, the Board Finance Committee determined which types of companies IAFNS wished to avoid or emphasize, along with the type of exposure to those companies that is acceptable. Thus, it was a survey to define criteria, determination of acceptable exposure, and identification of exclusions that allowed IAFNS to establish a Socially Responsible investment plan for our organization.
The value of an investment is no longer only about financial returns. An increasing number of investors are also calling for their money to make a positive impact on society and the world at large. For example, someinvestors and employees may be passionate aboutpromoting green business and embracing sustainability—others may be passionate about diversity, equity, and inclusion—others may be passionate about animal welfare. It’s natural extension for investors and employeesto ask if the organizations they support have similar commitments to invest according to their values? And, if not, why not?
Working with professional advisers, ESG investing—sometimes called Socially Responsible Investing—is a way to do more good with more money, expanding a non-profit organization’s positive effects beyond the activities of the organization to the entirely of its investment portfolio.
We encourage all other non-profits to review their investment policy. We encourage organizations to work with their Board and reflect on how their investments can additionally reflect their values.
By Wendelyn Jones, PhD,Executive Director of the Institute for the Advancement of Food and Nutrition Sciences (IAFNS)
<!–
–>